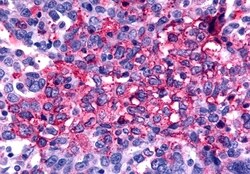
Invitrogen Frizzled-2 Polyclonal Antibody 50 &mu;g; Unconjugated:Antibodies,

missing translation for 'onlineSavingsMsg'
Learn More
Learn More
Invitrogen™ Frizzled-2 Polyclonal Antibody


Rabbit Polyclonal Antibody
Brand: Invitrogen™ PA533544
This item is not returnable.
View return policy
Description
Frizzled-2 Polyclonal Antibody for IHC (P)
This intronless gene is a member of the frizzled gene family. Members of this family encode seven-transmembrane domain proteins that are receptors for the wingless type MMTV integration site family of signaling proteins. This gene encodes a protein that is coupled to the beta-catenin canonical signaling pathway. Competition between the wingless-type MMTV integration site family, member 3A and wingless-type MMTV integration site family, member 5A gene products for binding of this protein is thought to regulate the beta-catenin-dependent and -independent pathways.
Specifications
| Frizzled-2 | |
| Polyclonal | |
| Unconjugated | |
| Fzd2 | |
| AL033370; AW456835; Dfrizzled2; Drosophila polarity gene (frizzled) homologue; Drosophila polarity gene homolog 2; frizzled 2, seven transmembrane spanning receptor; frizzled class receptor 2; frizzled family receptor 2; frizzled homolog 2; frizzled homolog 2 (Drosophila); frizzled-10; Frizzled-2; Fz10; fz-10; Fz2; Fz-2; Fzd10; Fzd2; fzE2; hFz2; Mfz10; Mfz10a; mFz2; rFz2 | |
| Rabbit | |
| Antigen affinity chromatography | |
| RUO | |
| 100050809, 100337669, 100350521, 100763109, 2535, 490937, 538507, 57265, 64512 | |
| Store at 4°C short term. For long term storage, store at -20°C, avoiding freeze/thaw cycles. | |
| Liquid |
| Immunohistochemistry (Paraffin) | |
| 1 mg/mL | |
| PBS with 0.1% sodium azide | |
| Q08464, Q14332, Q9JIP6 | |
| Fzd2 | |
| Synthetic 20 amino acid peptide from N-terminal extracellular domain of human Frizzled 2. | |
| 50 μg | |
| Primary | |
| Human, Mouse, Rat, Canine, Rabbit, Monkey, Bovine, Hamster, Pig, Horse | |
| Antibody | |
| IgG |
Product Content Correction
Your input is important to us. Please complete this form to provide feedback related to the content on this product.
Product Title
Spot an opportunity for improvement?Share a Content Correction